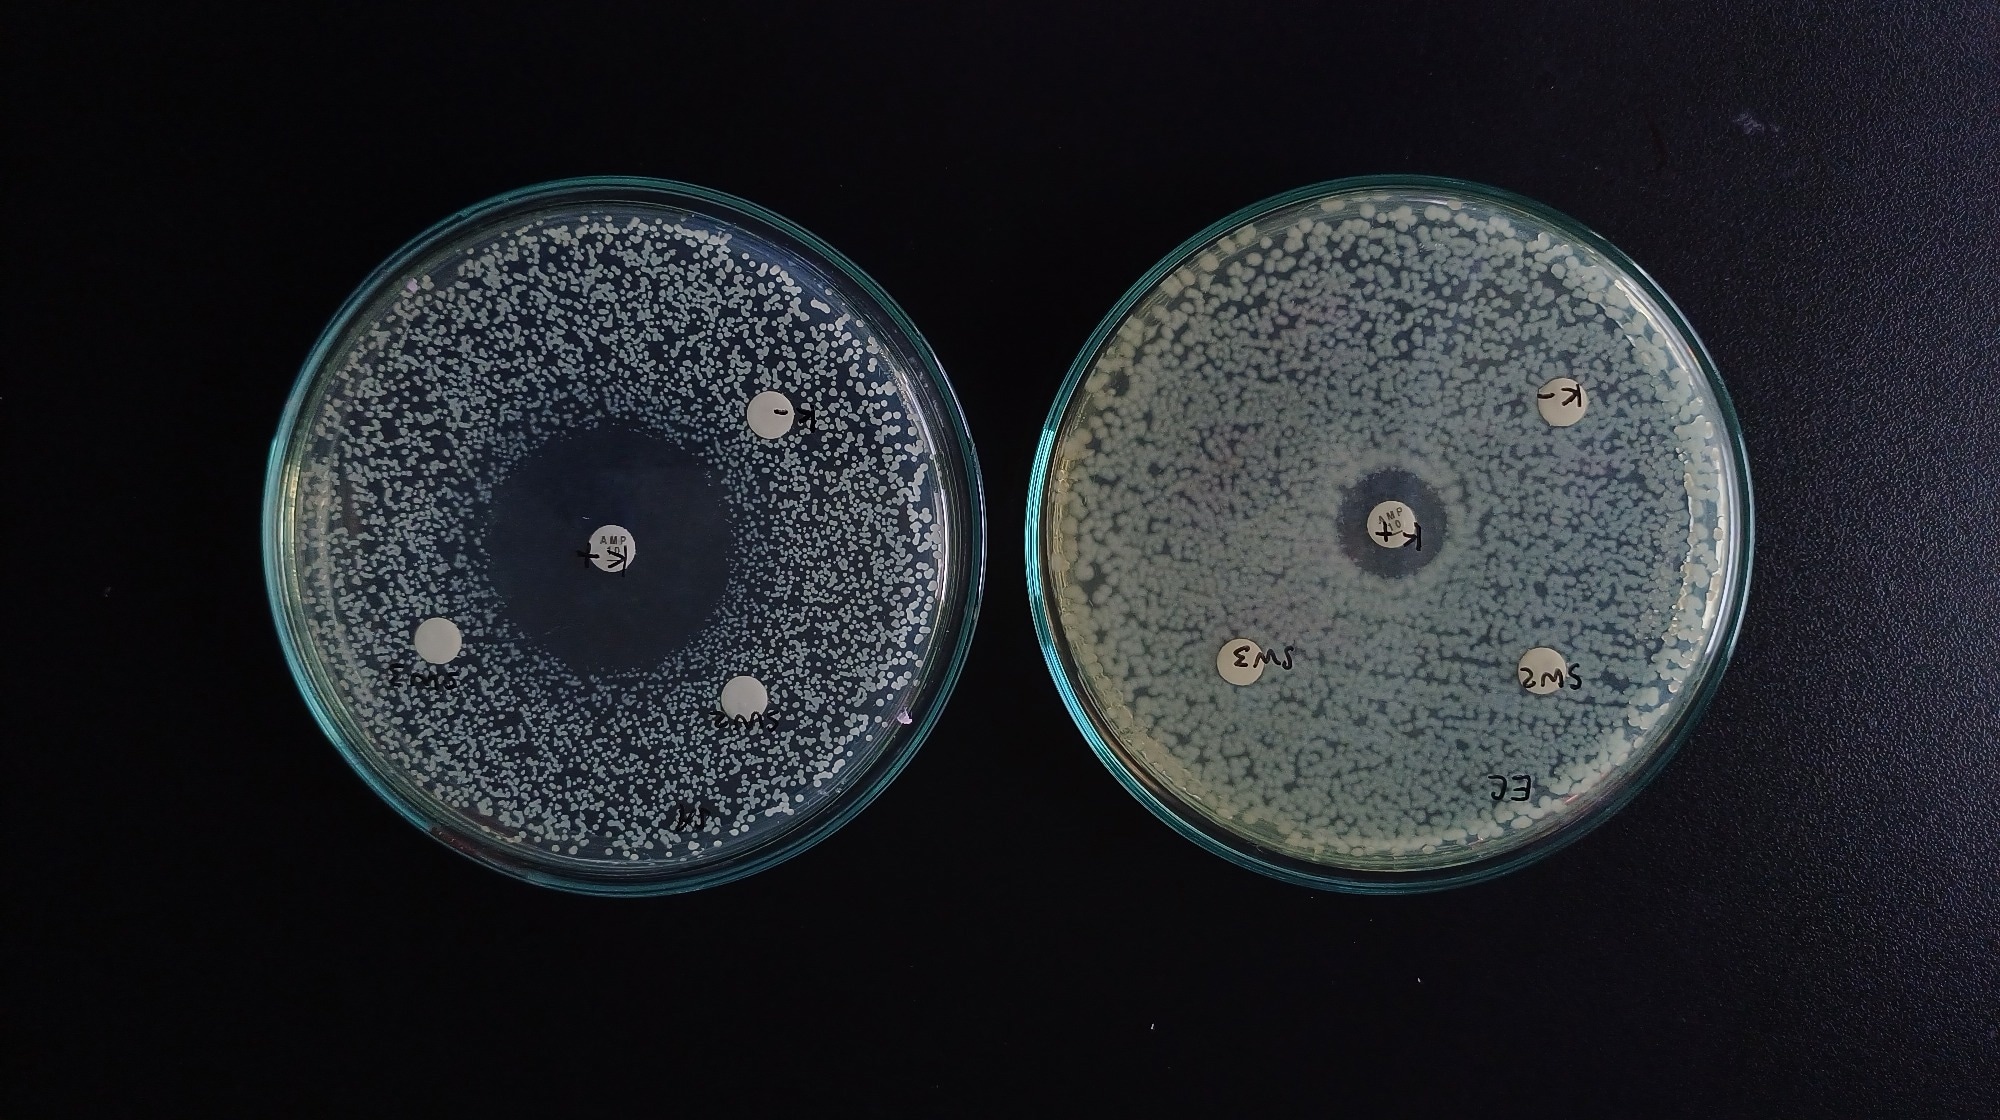

Introduction
What is antibiotic resistance?
What is antibiotic tolerance?
Key differences between resistance and tolerance
Mechanisms underlying antibiotic tolerance
Challenges in detection and measurement
Future directions and therapeutic implications
References
Further reading
Antibiotic resistance allows bacteria to grow despite antibiotic exposure, whereas antibiotic tolerance allows them to survive lethal treatment longer without increasing MIC. Understanding this distinction helps explain treatment failure, relapse, and the need for better diagnostics beyond standard susceptibility testing.
 Image Credit: Kateryna Kon / Shutterstock.com
Image Credit: Kateryna Kon / Shutterstock.com
Introduction
Antibiotic tolerance has emerged as an underrecognized survival strategy that enables bacteria to withstand lethal antibiotic exposure without altering susceptibility. Importantly, antibiotic treatment failure can occur even in the absence of resistance, making tolerance a distinct and potentially clinically relevant contributor to persistent infections.3 Understanding how antibiotic resistance differs from antibiotic tolerance is critical to improving treatment outcomes, particularly in cases of persistent and recurrent infections.
What is antibiotic resistance?
Antibiotic resistance refers to the inherited ability of bacteria to grow and proliferate in the presence of antibiotics that would normally inhibit or kill susceptible strains. In clinical settings, antibiotic resistance is typically measured by the minimum inhibitory concentration (MIC), which is defined as the lowest concentration of an antibiotic that inhibits bacterial growth under standardized conditions.
In resistant bacteria, the MIC is increased above clinically defined susceptibility thresholds, allowing bacterial growth at antibiotic concentrations that would inhibit susceptible strains.1,2 Bacteria acquire resistance through various mechanisms, including modification of the antibiotic target site, which reduces drug binding, as well as enzymatic inactivation of the antibiotic that renders it ineffective. Certain genetic mutations may also prevent intracellular drug accumulation by reducing uptake or by activating efflux pumps that expel the antibiotic. Together, these mechanisms reduce the effectiveness of antibiotics, enabling resistant bacteria to survive and grow even in concentrations of therapeutic drugs.2
What causes antibiotic resistance? - Kevin Wu
What is antibiotic tolerance?
Antibiotic tolerance is the ability of bacteria to survive exposure to otherwise lethal concentrations of antibiotics without growing or increasing their resistance. Crucially, tolerant bacteria exhibit an unchanged MIC compared with susceptible strains.2,3 Tolerant bacteria remain susceptible to antibiotic treatment based on standard measures, which leads to a reduced rate of antibiotic killing, rather than an increase in the concentration required to inhibit growth.
As a result, tolerance cannot be assessed by measuring MIC; instead, the minimum duration of killing (MDK) is used, which reflects the time required to kill a specified percentage of the bacterial population. This reflects a key distinction: tolerance affects the rate of bacterial killing over time, whereas resistance affects the concentration required to inhibit growth.1,3 Tolerance is often associated with physiological states like slow growth, quiescence, or activation of stress-response pathways that make bactericidal antibiotics that primarily target actively growing bacteria less effective. 1,2
Key differences between resistance and tolerance
Antibiotic resistance and tolerance represent distinct bacterial survival strategies with different clinical implications. Whereas resistance alters growth-based metrics routinely measured in clinical settings, tolerant bacteria persist without proliferating after antibiotic exposure, thereby enabling their survival even after the drug is removed. Importantly, tolerant populations are killed more slowly than they continue to grow, which distinguishes them mechanistically from resistant populations.2,3 Tolerance in bacteria may contribute to delayed clearance, persistent infections, and infection relapse, regardless of whether the strain is classified as susceptible or not.1,2,3
Mechanisms underlying antibiotic tolerance
While tolerance usually involves slower killing of the bacterial population as a whole, persistence occurs when most bacteria are rapidly eliminated, but a small subset survives for much longer. Thus, persistence is often described as a subpopulation-based form of tolerance and is commonly associated with biphasic killing dynamics.2,3 Both phenomena may involve stress responses and slowed metabolism; however, persistence differs in that survival is limited to a small minority of cells, rather than the entire bacterial population.
Antibiotic tolerance is due to various physiological and environmental factors that impact the efficacy of modern antibiotics. Decreased metabolic activity or slow bacterial growth, for example, limits the activity of antibiotics that target active processes like cell wall synthesis or deoxyribonucleic acid (DNA) replication. This reduction in growth and metabolism is a central physiological basis of tolerance across many bacterial species.3
Stress-response pathways triggered by nutrient deprivation, oxidative damage, or host defense can induce protective states that facilitate bacterial survival. For example, activation of the stringent response via (p)ppGpp signaling can downregulate metabolism and contribute to antibiotic tolerance.3 Changes in essential cellular functions, including energy generation and macromolecule synthesis, can increase the tolerance of bacteria to antibiotics.1,2 Biofilm formation also contributes to antibiotic tolerance, as these bacteria are protected from antibiotic penetration and exist in altered microenvironments that promote antibiotic tolerance.2,3
Image Credit: Krisan_84 / Shutterstock.com
Image Credit: Krisan_84 / Shutterstock.com
Challenges in detection and measurement
Antibiotic tolerance is increasingly recognized as an important contributor to poor clinical outcomes like treatment failure, prolonged infections, and relapse, even when pathogens are classified as susceptible based on standard testing. Standard antimicrobial susceptibility tests primarily measure growth inhibition by MIC and therefore do not capture bacterial survival dynamics well.1,2 Since routine diagnostic testing is designed to measure growth inhibition, rather than the survival of bacteria, many cases of tolerance are undiagnosed.
Emerging approaches like MDK measurements and time-kill assays provide more accurate insights into bacterial survival dynamics. Time-kill assays are widely regarded as the gold standard for detecting tolerance in research settings because they quantify killing rates over time, although the lack of standardized methods and interpretation criteria still limits broader clinical use.3 However, different methods and interpretation limit their regular use, thus emphasizing the importance of establishing more accurate and standardized diagnostic tools to identify and measure antibiotic tolerance in clinical settings.2,3
Future directions and therapeutic implications
Future strategies should maximize treatment effectiveness and reduce the number of infections that persist due to their persistence and/or resistance to antibiotics. Because tolerant and persister cells can survive antibiotic exposure and potentially reseed infections after treatment, targeting these populations may improve outcomes in some settings.1 A growing interest has emerged in combination therapies that target both actively growing bacteria and persistently tolerant cells.
Current approaches to diagnosing and treating infections are inadequate because they focus solely on addressing antibiotic resistance. Therefore, alternative strategies that account for both antibiotic resistance and tolerance are needed to improve patient outcomes and address antimicrobial failure.
There remains an urgent need to develop new drugs that disrupt tolerance mechanisms or improve antibiotic killing. Additionally, reducing tolerance may help limit the evolution of antibiotic resistance by decreasing the pool of surviving bacteria.1 Beyond drug development, incorporating tolerance into clinical guidelines and antimicrobial susceptibility testing could further refine the selection of treatment options for patients, thereby improving overall outcomes.1,3
References
- Boeck, L. (2023). Antibiotic tolerance: targeting bacterial survival. Current Opinion in Microbiology 74. DOI: 10.1016/j.mib.2023.102328. https://www.sciencedirect.com/science/article/pii/S1369527423000656
- Brauner, A., Fridman, O., Gefen, O., & Balaban, N. Q. (2016). Distinguishing between resistance, tolerance, and persistence to antibiotic treatment. Nature Reviews Microbiology. 14(5). 320-330. DOI: 10.1038/nrmicro.2016.34. https://www.nature.com/articles/nrmicro.2016.34
- Deventer, A. T., Stevens, C. E., Stewart, A., & Hobbs, J. K. (2024). Antibiotic tolerance among clinical isolates: mechanisms, detection, prevalence, and significance. Clinical Microbiology Reviews 37(4). DOI: 10.1128/cmr.00106-24. https://journals.asm.org/doi/10.1128/cmr.00106-24
Further Reading
Last Updated: Apr 21, 2026